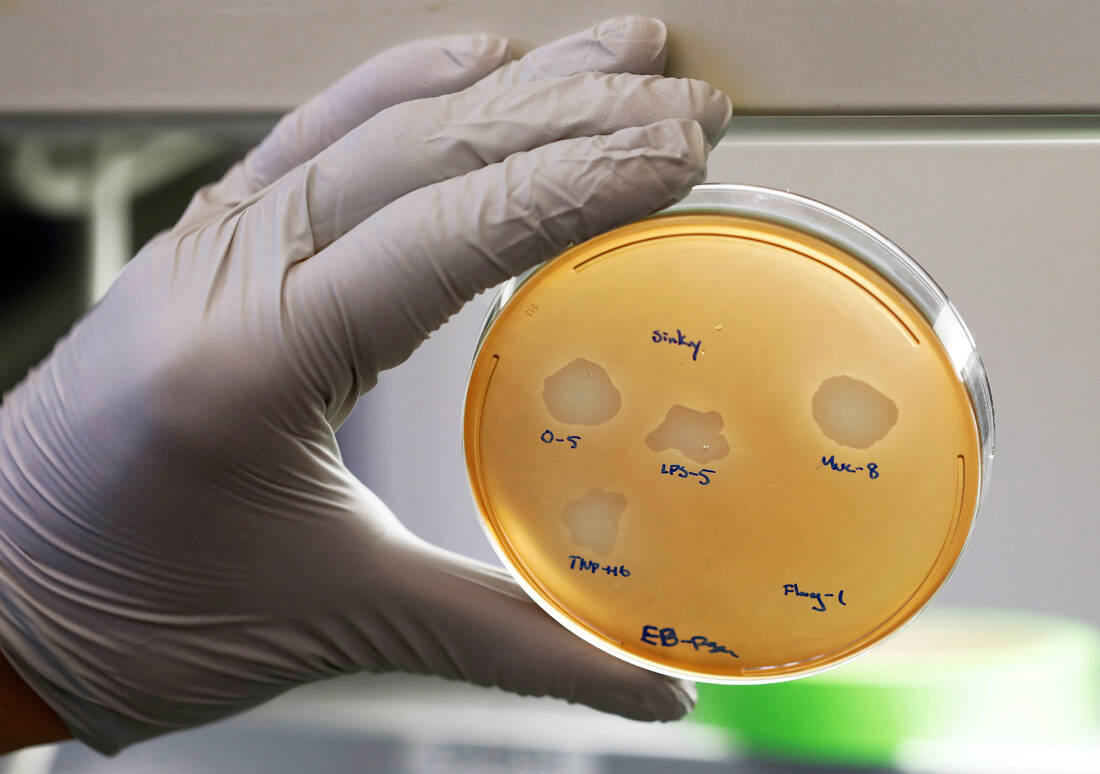

Τον Φεβρουάριο του 2019, ο Παγκόσμιος Οργανισμός Υγείας είχε σημάνει συναγερμό για την κυκλοφορία ψεύτικων εμβολίων για τη μηνιγγίτιδα στον Νίγηρα. Ο Οργανισμός ζητούσε αυξημένη επαγρύπνησε σε όλα τα επίπεδα της προμηθευτικής αλυσίδας, ειδικά στη δυτική Αφρική, καθώς είχε διαπιστωθεί πως ο αριθμός παρτίδας και η ημερομηνία λήξης των εμβολίων δεν ταίριαζαν με τα αρχεία κανενός παρασκευαστή των αυθεντικών σκευασμάτων.
Τον ίδιο μήνα, ο ΠΟΥ είχε προειδοποιήσει για την κυκλοφορία ψεύτικων φαρμάκων για την υπέρταση στο Καμερούν, τα οποία περιείχαν αντί για την προβλεπόμενη ουσία, μία άλλη, που χρησιμοποιείται για την αντιμετώπιση του διαβήτη, και προκαλούσε τα αντίθετα αποτελέσματα στους ασθενείς που τα πήραν.
Τα τελωνεία της χώρας είχαν ήδη κατασχέσει χιλιάδες φάρμακα αμφισβητούμενης ποιότητας.

Οι υποθέσεις αυτές, στο Καμερούν και τη Νιγηρία, δεν ήταν ούτε οι τελευταίες ούτε οι μόνες στην Αφρική, όπου ο ατυχής συνδυασμός δοκιμαζόμενων οικονομιών, αδύναμου ρυθμιστικού πλαισίου και καταναλωτών με ανεπαρκή εκπαίδευση κάνει πολλές χώρες πολύ ευάλωτες στη δράση κυκλωμάτων που αποσκοπούν στο εύκολο κέρδος, αδιαφορώντας για τις συνέπειες στις ανθρώπινες ζωές.
Μάλιστα τα τελευταία χρόνια το λαθρεμπόριο από την Ινδία και την Κίνα έχει γίνει πιο εύκολο, καθώς πολλά νόμιμα και γνήσια φάρμακα προέρχονται από τις χώρες αυτές.
Οι αφρικανικές χώρες είναι επίσης ευάλωτες επειδή η νόμιμη φαρμακευτική αγορά αναπτύσσεται ταχύτατα ακολουθώντας την αύξηση κι επέκταση του πληθυσμού. Σύμφωνα με τη εταιρεία συμβούλων McKinsey, η αξία της φαρμακευτικής βιομηχανίας στην Αφρική αναμένεται φέτος να διπλασιαστεί ή και να τριπλασιαστεί φτάνοντας τα 40 με 65 δισεκατομμύρια δολάρια.
Αυτό κάνει τον κλάδο ελκυστικό τόσο στους πραγματικούς παίκτες του φαρμακευτικού τομέα όσο και σε ανθρώπους που δραστηριοποιούνται είτε στο περιθώριο είτε σε καθεστώς παρανομίας.

Πλέον γίνεται λόγος για κρίση της δημόσιας υγείας. Επτά αφρικανικές χώρες είχαν συνάντηση τον περασμένο μήνα στο Τόγκο, προκειμένου να συστήσουν μέτωπο απέναντι στο διογκούμενο πρόβλημα. Κονγκό, Νίγηρας, Σενεγάλη, Τόγκο, Ουγκάντα, Γκάνα και Γκάμπια συζήτησαν μέτρα για να αντιμετωπίσουν της διακίνηση των πλαστών φαρμάκων, τομές που εξακολουθεί να αναπτύσσεται σε βάρος προφανώς της ανθρώπινης ζωής.

Παγκοσμίως, το εμπόριο ψευδεπίγραφων φαρμακευτικών προϊόντων αποτιμάται στα 200 δισεκατομμύρια δολάρια, με την Αφρική να είναι από τις περιοχές που πλήττονται περισσότερο, σύμφωνα με τις εκτιμήσεις. Σύμφωνα με τον Παγκόσμιο Οργανισμό Υγείας, το 42% όλων των πλαστών φαρμάκων μεταξύ 2013 και 2017- που ήρθαν σε γνώση του οργανισμού- προερχόταν από την Αφρική
Από Ευρώπη και Βόρεια και Νότια Αμερική προερχόταν μόλις το 21%.

Ο Παγκόσμιος Οργανισμός Υγείας διαθέτει μηχανισμό καταγραφής που στηρίζεται στις εθνικής ή περιφερειακές ρυθμιστικές αρχές σε όλο τον κόσμο, οι οποίες καλούνται να τον ειδοποιούν όταν κατάσχουν φορτία με πλαστά φάρμακα. Οπότε τα στοιχεία για την περίοδο που προαναφέρθηκε αφορούν μόνο όσες υποθέσεις έφτασαν μέχρι τον Οργανισμό μέσω των εθνικών ρυθμιστικών αρχών.
Ο ίδιος ο ΠΟΥ έχει επισημάνει πως όσο περισσότερο εκπαιδεύονταν νέοι εργαζόμενοι και όσο περισσότερο δραστηριοποιούνταν οι εθνικές ρυθμιστικές αρχές, τόσο περισσότερο αυξάνονταν οι αναφορές κατασχέσεων. Οπότε είναι πιθανό περιοχές με αδύναμα τέτοια συστήματα να μην είναι σε θέση να καταγράψουν και να αναφέρουν το πρόβλημα στην πραγματική του έκταση.

Ο Bright Simons, που έστησε ένα κινητό σύστημα για την επικύρωση της γνησιότητας φαρμάκων στην Γκάνα, τονίζει πως δεν είναι εφικτό να υπάρξει ακριβής εκτίμηση, καθώς το εμπόριο γίνεται εν κρυπτώ.
Έχουν όμως γίνει πολλές κατασχέσεις τα τελευταία χρόνια, οι οποίες δίνουν ένα στίγμα της έκτασης του προβλήματος στη Δυτική Αφρική:
-Η Ακτή του Ελεφαντοστού, η Γουινέα- Μπισάου, η Λιβερία και η Σιέρα Λεόνε κατέσχεσαν 19 τόνους πλαστών φαρμάκων το 2018.
-Λαθρέμποροι στην Ακτή του Ελεφαντοστού συνελήφθησαν ενώ επιχειρούσαν να εισαγάγουν στην χώρα 12 τόνους ψεύτικων φαρμάκων από την Γκάνα το 2019.
-Το 2016, στο πλαίσιο επιχείρησης υπό την Ιντερπόλ σε επτά χώρες της Δυτικής Αφρικής κατασχέθηκαν πάνω από 420 τόνοι πλαστών φαρμακευτικών προϊόντων.
-Σχεδόν 19,88 τόνοι ψεύτικων φαρμάκων κατασχέθηκαν στο Μαλί μεταξύ 2015-2018.

Η εταιρεία PwC εξηγεί πως το ποσοστό ψεύτικων φαρμακευτικών προϊόντων φτάνει ακόμα και το 70% σε αναπτυσσόμενες περιοχές όπως η Αφρική.
Ο ΠΟΥ εκτιμά πως ένα στα δέκα φάρμακα στις χώρες με χαμηλά ή και μεσαία εισοδήματα, στις οποίες περιλαμβάνονται οι περισσότερες χώρες της Αφρικής, είτε είναι πλαστό είτε υπολείπεται σε ποιότητα.

Οι αναλύσεις του London School of Hygiene and Tropical Medicine για λογαριασμό του ΠΟΥ έδειξαν πως τα κατώτερης ποιότητας ή ψεύτικα φάρμακα για την ελονοσία ενδέχεται να προκαλούν 116.000 επιπλέον θανάτους κάθε χρόνο στην υποσαχάρια Αφρική, με σημαντικό κόστος για τους ασθενείς και τα συστήματα υγείας, στα 38,5 εκατομμύρια δολάρια τον χρόνο, κατά μέσο όρο.
Το 2015, έρευνα που δημοσιεύτηκε στο American Society of Tropical Medicine and Hygiene εκτίμησε πως τα κατώτερα σε ποιότητα φάρμακα για την ελονοσία στην υποσαχάρια Αφρική στοίχιζαν κάθε χρόνο πάνω από 122.000 θανάτους παιδιών ηλικίας κάτω των 5 ετών.
Παρότι τα αποτελέσματα αυτά είναι μόνο εκτιμήσεις, οι επιστήμονες λένε πως είναι ενδεικτικά του ότι τα φάρμακα κακής ποιότητας παίζουν σημαντικό ρόλο στα ποσοστά θανάτων παιδιών κάτω των πέντε ετών.

Τα ψεύτικα φάρμακα είναι δύσκολο να διαχωριστούν από τα κανονικά, με τη συσκευασία τους να είναι πολλές φορές εξίσου καλή αν και όχι και καλύτερη από αυτή των γνήσιων.
Αδύναμα ή και ανύπαρκτα νομικά πλαίσια και η έλλειψη κανονισμών αναφορικά με τις πωλήσεις- που γίνονται online ή και από τοποθεσίες χωρίς τις προβλεπόμενες άδειες- είναι παράγοντες που επιτείνουν το πρόβλημα, όπως επισημαίνει ο ΟΗΕ.

Και υπάρχει εν γένει το πρόβλημα του κόστους των φαρμάκων στις πιο φτωχές χώρες.
«Εάν ένα φάρμακο καλής ποιότητας από έναν γνωστό προμηθευτή είναι πολύ ακριβό, ο κόσμος είναι πιθανό να δοκιμάσει ένα πιο φτηνό από κάποιον που τη διαθέτει χωρίς άδεια» εξηγεί ο ΠΟΥ. Ωστόσο η μείωση των τιμών σε φάρμακα που κυκλοφορούν με άδεια δεν εγγυάται λύση του προβλήματος. Ακόμα και τα φάρμακα χαμηλού κόστους μπορούν να επιφέρουν κέρδος για τους εγκληματίες- εφόσον ο όγκος των πωλήσεων είναι αρκετά μεγάλος.
Μία πιθανή λύση φαίνεται τελικά να δίνει η τεχνολογία. Είτε με εφαρμογές στα κινητά, που βοηθούν τους χρήστες να βεβαιώσουν τη γνησιότητα ενός φαρμάκου, είτε με «ξυστά» αυτοκόλλητα, είτε με barcodes και άλλα μέσα ταυτοποίησης, δείχνει να υπάρχει τρόπος να γίνουν κινήσεις στην κατεύθυνση περιορισμού του προβλήματος.